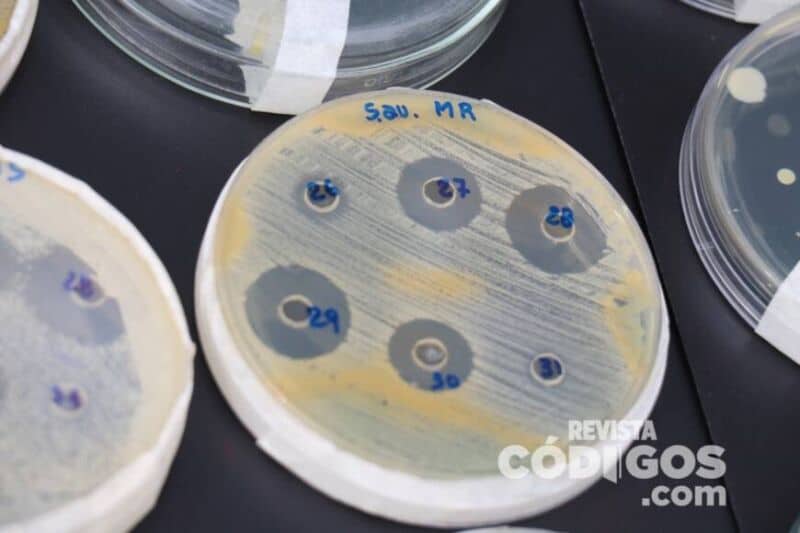
Semana de la Ciencia y la Tecnología: Kermes Científica IV en la plaza 9 de Julio 1 2 - kermes cientifica 1 - 1

La actividad se lleva cabo desde la mañana de este jueves en la plaza posadeña. Participan unos 25 proyectos científicos.
“Normalmente, en tiempos de no pandemia, el evento se hacía en septiembre, pero lo importante hoy es que logramos volver a la plaza y estamos felices por ello, teniendo en cuenta que el año pasado lo hicimos desde la virtualidad”, expresó a Códigos Tatiana Schmalko, representante del programa de Divulgación Científica de la Universidad Nacional de Misiones.
Por la tarde de esta misma jornada, se prevé charlas en simultáneo y la presencia de distintas universidades que se encuentran la capital provincial
“Desde el programa tratamos de mostrar todo lo que hacemos, y que todos los proyectos son en pos del beneficio de la sociedad misionera y la región, desde el ámbito de la salud, la industria, biológico, medioambiente, entre otros aspectos”, remarcó.
Por otra parte, Inés Badano, docente universitaria y una de las expositoras en el lugar mostró aspectos de la Antropolgía Biológica, una disciplina que estudia los orígenes de la humanidad. Indicó que desde 2022 se pondrá en marcha el proyecto “Orígenes” que acercará a la gente – a través de murales con arte y tecnologías inversivas- fósiles de la evolución humana “para conocer nuestra historia desde la paleo antropología”.